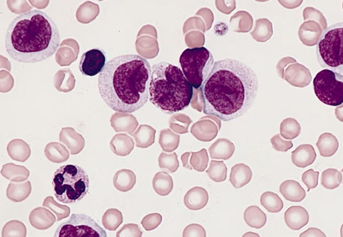

Featured Media
Academic Journal Articles
News Stories

25.04.2026
- Subscription

26.05.2025

10.10.2024

26.09.2023

21.04.2023
- Subscription

10.08.2018
- Subscription

03.02.2015

31.05.2011
Videos & Podcasts

28.05.2024
- Podcast

24.01.2024
- Video

08.2023 →
- Podcast

06.05.2021
- Video

15.02.2021
- Video
Webinars


07.10.2022
- With registration